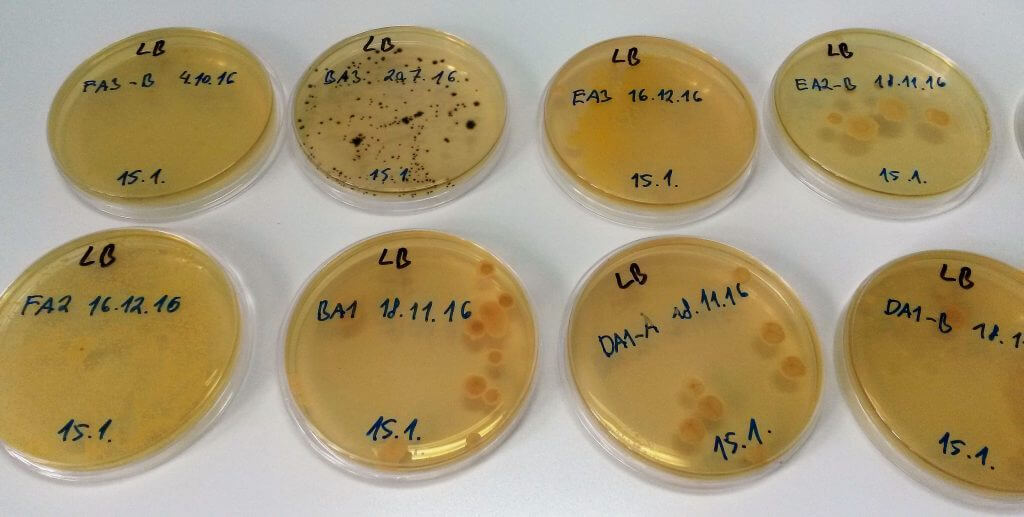

Vedúci oddelenia
Oblasti výskumu
- Zvýšenie tolerancie okrasných výsadieb voči abiotickým stresorom pre ich stabilizáciu v podmienkach klimatickej zmeny/mestských aglomerácií – v previazanosti na introdukčný program allochtónnej dendroflóry v Arboréte Mlyňany
- Analýza dynamiky endofytického mikrobiómu v okrasných drevinách vo vzťahu k environmentálnych a biologických faktorov, bioprospecting endofytov v medicíne a poľnohospodárstve (skríning produkcie sekundárnych metabolitov)
- Nastavenie in vitro protokolov pre mikropropagáciu atraktívnych genotypov drevín
- Biotechnológie pre zvýšenie produkcie farmakologicky aktívnych látok v pletivách drevín
- Mapovanie trojcestných interakcií medzi rastlinami, článkonožcami a mikróbmi, účinnosti mikróbov v boji s ochoreniami rastlín a vzťahu pH a kompozície mikrobiómu (meta-analýza súčasného poznania s použitím štatistickej analýzy a modelovania)
- Štúdium úlohy parametrov rastu, reprodukčnej biológie a ekologickej plasticity v inváznom procese drevín, predikcia budúcich invázií
- Identifikácia nových bioherbicídov účinných proti najnebezpečnejším inváznym drevinám, popis mechanizmu ich účinku
Ciele
- zvýšiť toleranciu introdukovaných drevín voči abiotickému stresu pre stabilizáciu okrasných výsadieb v podmienkach klimatickej zmeny/urbánneho prostredia
- lepšie pochopiť sezónnu dynamiku rastlinného endofytického mikrobiómu a faktorov definujúcich endofytickú komunitu, identifikovať endofyty podporujúce rast a/alebo toleranciu rastlín voči stresu ako aj antimikrobiálnu aktivitu pre ochranu rastlín/medicinálne využitie
- vypracovať protokoly pre efektívnu mikropropagáciu atraktívych okrrasných drevín
- formulovať biotechnologické metódy pre maximalizáciu produkcie
- popísať všeobecné vzory, medzery v poznatkoch a najvýznamnejšie účinky trojcestných interakcií rastlina-článkonožec-mikroorganizmus na dreviny za účelom predikcie výstupov týchto komplexných interakcií
- odhaliť pozadie prechodu nepôvodných drevín k inváznemu správaniu
- identifikovať allelopatiká/bioherbicídy účinné boji s najnebezpečnejšími inváznymi drevinami